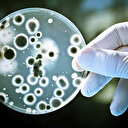

ABD Başkanı Donald Trump koronavirüs nedeniyle ülke olarak aldıkları tedbirler ile ilgili ulusa seslendi. Trump, AB'den ABD'ye 30 günlük süre boyunca seyahatleri yasakladığını duyururken,kararın cuma günü itibariyle yürürlüğe gireceğini ve Türkiye ile İngiltere'nin yasaktan muaf olacağını belirtti. ABD Başkanı Trump ayrıca Avrupa Birliği'nin gerekli önlemleri almada başarısız olduğunu da söyledi.
Trump, ABD'nin yeni tip koronavirüs (Kovid-19) salgınına ilişkin aldığı önlemler konusunda, Oval Ofis'ten yapılan yayınla ulusa seslendi.
*Cuma gününden itibaren AB'den ABD'ye 30 gün için bütün seyahatleri yasaklıyoruz. (İngiltere hariç)
*Virüsle mücadelede sağlık sigortasında bürokrasiyi azalttık.- *Virüs taşıyan insanların için kongreden yardım talep edeceğim.
- *Başka hiçbir ülke bizden daha iyi hazırlanmış değil. Dünyanın en iyi doktorları bizdedir.
Avrupa'ya kapılar 30 gün kapalı
AB tedbir almakta başarısız oldu
İstisnalar olacak
İngiltere muaf tutulacak
Bu kısıtlamaların ticaret ve kargoyu etkilemeyeceğini kaydeden Trump, bu uygulamadan İngiltere'nin de muaf tutulacağını kaydetti.
- Trump, Çin ve Güney Kore'deki durumu da izlediklerini, durumlarının iyileşmesi durumunda bu ülkelere karşı alınan önlemleri de yeniden değerlendireceklerini belirtti.
Yaşlı Amerikalılar dikkatli olmalı
Dünya Sağlık Örgütünün bugün yaptığı açıklamada Kovid-19 salgınını “pandemi” ilan ettiğine dikkati çeken Trump, "Müttefiklerimizle sürekli iletişim halindeyiz. Federal hükümetin ve özel sektörün tüm gücünü Amerikan halkını korumak için seferber ediyoruz."ifadesini kullandı.
Kovid-19 salgınına yönelik birçok erken tedbir aldıklarını bu nedenle de şu anda Avrupa’ya kıyasla daha az vaka olduğunu belirten Trump, şu açıklamalarda bulundu:
- "Amerikanların çoğunluğu için risk çok çok düşük. Genç ve sağlıklı insanlar, kendilerine virüs bulaşırsa hızlı bir iyileşme bekleyebilir. En büyük risk, sağlık sorunu olan yaşlı insanlar için. Bu nüfus çok çok dikkatli olmalı. Bakım evlerine tüm zaruri olmayan ziyaretleri askıya almalarını tavsiye ediyoruz. Genel olarak yaşlı Amerikalılar, kalabalık alanlara gerekli olmadıkça girmemeli."
Küçük bir eylem, yarın virüsün önüne geçecek
Trump ekonomik önlemleri de açıkladı
Trump, antiviral tedavileri rekor sürede gerçekleştirebilmek için bürokraside azalmaya gideceklerini belirterek, geçen hafta imzaladığı 8,3 milyar dolarlık fonla Hastalık Kontrol ve Önleme Merkezleriyle diğer kamu kurumlarının virüsle mücadelesine yardımcı olunacağını, aşı, tedavi ve tıbbi malzeme tedariğinin destekleneceğini bildirdi.
Bu finansal bir kriz değil
- Trump, “Bu finansal bir kriz değil. Bu sadece ulusça ve dünyaca beraber üstesinden geleceğimiz geçici bir durum.” dedi.
- Küçük İşletmeler İdaresine Kovid-19’dan etkilenen firmalara sermaye ve likidite sağlamasına yönelik talimat verdiğine dikkati çeken Trump, düşük faizli kredilerin virüs kaynaklı geçici ekonomik sıkıntılarının üstesinden gelmeleri için küçük işletmelere yardımcı olacağını, söz konusu idarenin salgından etkilenen eyaletlerde kredi sağlamaya başlayacağını ve Kongre’den bu program için 50 milyar dolarlık ilave kaynak artırımına gitmesini istediğini söyledi.
- Trump, acil durum yetkisini kullanarak, salgından olumsuz etkilenen kişiler ve işletmeler için faiz veya ceza uygulanmaksızın vergi ödemelerinde ertelemeye gidilmesi için Hazine Bakanlığına talimat vereceğini belirterek, “Bu ekonomiye 200 milyar dolardan fazla ilave likidite sağlayacaktır.” diye konuştu.
- Başkan Trump, çalışanların maaşları üzerinden yapılan vergi kesintilerinin hafifletilmesi için Kongre’ye çağrıda bulundu.
Türkiye de muaf sayılacak
Öte yandan Trump’ın ulusa seslenişte Avrupa ülkelerinden seyahati kısıtlayacaklarını duyurmasının ardından İç Güvenlik Bakanlığı da yazılı bir açıklama yayımladı.
Açıklamada, "Bugün Başkan Trump, bazı Avrupa ülkelerinden birinde olan ya da ABD’ye varış tarihinden önceki 14 gün içerisinde olan yabancı ülke vatandaşlarının birçoğunun ülkeye girişini askıya alınmasını öngören bir kararname imzaladı." ifadelerine yer verildi.
Seyahat kısıtlaması getirilen ülkeler arasında Türkiye bulunmazken, düzenlemeden etkilenecek ülkelerin Şengen ülkeleri olarak da bilinen, Avusturya, Belçika, Çekya, Danimarka, Estonya, Finlandiya,Fransa, Almanya, Yunanistan, Macaristan, İzlanda, İtalya, Letonya, Lihtenştayn, Litvanya, Lüksemburg, Malta, Hollanda, Norveç, Polonya, Porteiz, Slovakya, Slovenya, İspanya, İsveç ve İsviçre olduğu kaydedildi.
Trump’ın Colorado ve Nevada seyahatleri iptal
- Öte yandan Trump’ın ulusa sesleniş konuşmasının ardından, Beyaz Saray Sözcüsü Stephanie Grisham bir açıklama yaparak başkanın bazı seyahatlerinin Kovid-19 nedeniyle iptal edildiğini duyurdu.
- Grisham açıklamasında, "Kovid-19 salgını nedeniyle tedbir amacıyla, Başkan Trump, Colorado ve Nevada’da yapmayı planladığı etkinlikleri iptal etme kararı aldı." ifadesine yer verdi.